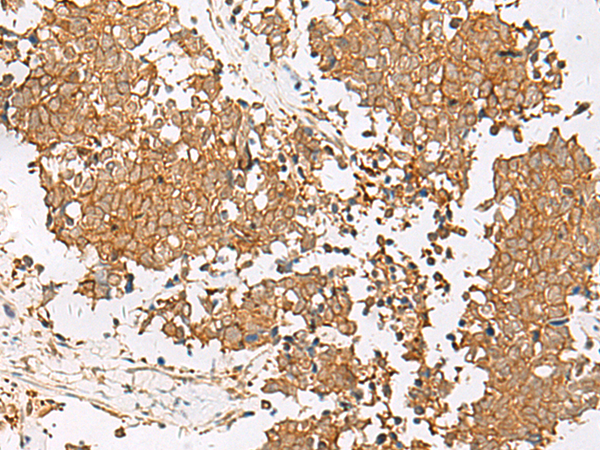

中文名稱: 兔抗GSTM2多克隆抗體
英文名稱: Anti-GSTM2 rabbit polyclonal antibody
別 名: glutathione S-transferase mu 2; GST4; GSTM; GTHMUS; GSTM2-2
相關(guān)類別: 一抗
儲 存: 冷凍(-20℃)
抗 原: GSTM2
宿 主: Rabbit
反應(yīng)種屬: Human, Mouse
標(biāo) 記 物: Unconjugate
克隆類型:rabbit polyclonal
Background:
Cytosolic and membrane-bound forms of glutathione S-transferase are encoded by two distinct supergene families. At present, eight distinct classes of the soluble cytoplasmic mammalian glutathione S-transferases have been identified: alpha, kappa, mu, omega, pi, sigma, theta and zeta. This gene encodes a glutathione S-transferase that belongs to the mu class. The mu class of enzymes functions in the detoxification of electrophilic compounds, including carcinogens, therapeutic drugs, environmental toxins and products of oxidative stress, by conjugation with glutathione. The genes encoding the mu class of enzymes are organized in a gene cluster on chromosome 1p13.3 and are known to be highly polymorphic. These genetic variations can change an individual's susceptibility to carcinogens and toxins as well as affect the toxicity and efficacy of certain drugs.
Applications:
ELISA, WB
Name of antibody:
GSTM2
Immunogen:
Fusion protein of human GSTM2
Full name:
glutathione S-transferase mu 2
Synonyms:
GST4; GSTM; GTHMUS; GSTM2-2
SwissProt:
P28161
ELISA Recommended dilution:
5000-10000
WB Predicted band size:
26 kDa
WB Positive control:
Mouse liver tissue lysate
WB Recommended dilution:
1000-5000
技術(shù)規(guī)格

購物車
購物車 幫助
幫助
 021-54845833/15800441009
021-54845833/15800441009
